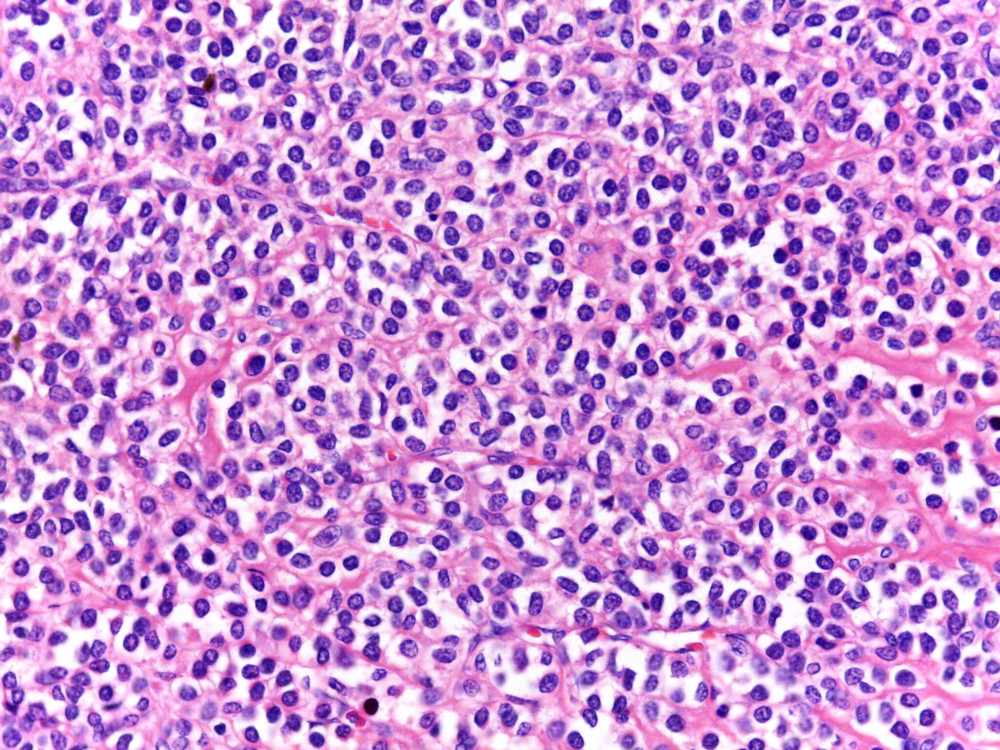

Mujer de 50 años con sangrado de tubo digestivo
Por endoscopia se identifica un tumor en antro gástrico

CD34:

Desmina:

AML:

Respuesta:
Este caso demostro negatividad para CD117 y DOG 1
Diagnóstico: Tumor glómico gástrico
Am J Surgical Pathology 2002;26:301
Am J Surgical Pathology 2020; 44:1556